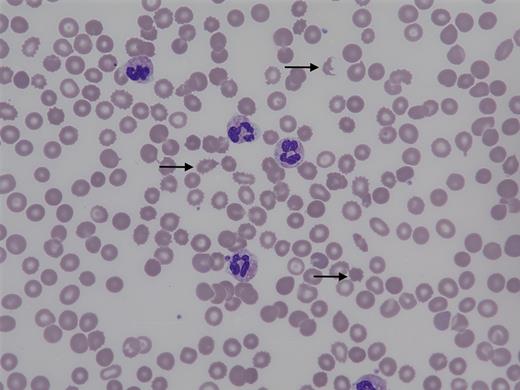
Peripheral blood smear before treatment (magnification x600)

A 42-year-old white man presented with jaundice and generalized edema. He had been diagnosed with alcoholic cirrhosis four months prior. Laboratory evaluation is summarized in the Table. Abdominal ultrasound revealed a nodular liver and splenomegaly of 15.6 cm in craniocaudal dimension. Peripheral blood smear (panel A) revealed spur cells (acanthocytes, arrows). Hospital course was complicated by hematemesis and acute kidney injury requiring dialysis.
| Test . | Result . | Reference Range . |
|---|---|---|
| Hemoglobin | 8.8 g/dL | 14-17 g/dL |
| Mean cell volume | 100 fL | 81-96 fL |
| Platelet count | 119 × 109/L | 150-425 × 109/L |
| White cell count | 11.4 × 109/L | 4.5-11 × 109/L |
| Reticulocytes | 5% | 0.4-1.9% |
| Vitamin B12 | > 1,500 pg/mL | 225-914 pg/mL |
| Folate | 12.4 ng/mL | ≥ 5.9 ng/mL |
| Ferritin | 955 ng/mL | 22-350 ng/mL |
| Creatinine | 0.75 mg/dL | 0.4-1.3 mg/dL |
| Blood urea nitrogen | 17 mg/dL | 6-26 mg/dL |
| Total/direct bilirubin | 14.2/5.6 mg/dL | 0.2-1.3/0-0.3 mg/dL |
| International normalized ration (INR) | 3.46 | 0.9-1.1 |
| Fibrinogen | 69 mg/dL | 200-400 mg/dL |
| Haptoglobin | < 30 mg/dL | 44-215 mg/dL |
| Direct antiglobulin (Coombs) test | Negative | Negative |
| Test . | Result . | Reference Range . |
|---|---|---|
| Hemoglobin | 8.8 g/dL | 14-17 g/dL |
| Mean cell volume | 100 fL | 81-96 fL |
| Platelet count | 119 × 109/L | 150-425 × 109/L |
| White cell count | 11.4 × 109/L | 4.5-11 × 109/L |
| Reticulocytes | 5% | 0.4-1.9% |
| Vitamin B12 | > 1,500 pg/mL | 225-914 pg/mL |
| Folate | 12.4 ng/mL | ≥ 5.9 ng/mL |
| Ferritin | 955 ng/mL | 22-350 ng/mL |
| Creatinine | 0.75 mg/dL | 0.4-1.3 mg/dL |
| Blood urea nitrogen | 17 mg/dL | 6-26 mg/dL |
| Total/direct bilirubin | 14.2/5.6 mg/dL | 0.2-1.3/0-0.3 mg/dL |
| International normalized ration (INR) | 3.46 | 0.9-1.1 |
| Fibrinogen | 69 mg/dL | 200-400 mg/dL |
| Haptoglobin | < 30 mg/dL | 44-215 mg/dL |
| Direct antiglobulin (Coombs) test | Negative | Negative |